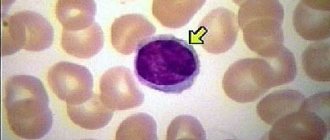

Общие сведения о патологии
В народе кардиомегалию называют “бычьим” сердцем. Это связано с тем, что сердце значительно увеличивается в размерах. В норме этот орган весит у мужчин от 270 до 370 г, а у женщин – 200 – 300 г. При патологии вес сердца может достигать 600 – 900 г.
При кардиомегалии наблюдается увеличение в размерах всех полостей сердца. Полости желудочков или предсердий могут растягиваться в 2 и более раз. Также наблюдается гипертрофия и утолщение сердечной мышцы.
Изменение размеров миокарда приводит к функциональным расстройствам, развитию прогрессирующей сердечной недостаточности. У больного возникают различные нарушения ритма и проводимости, симптомы застойных явлений по большому кругу кровообращения.
При врожденной патологии дети погибают в возрасте до 3-х месяцев либо остаются тяжелыми инвалидами.
Как относиться к болям в сердце?
Кардиомегалия не является симптомом ишемической болезни. Но перенесенный острый инфаркт, длительные приступы стенокардии стабильного и нестабильного типа, признаки атеросклероза могут привести к гипертрофии и дилатации (расширению полостей) сердца. Аневризма левого желудочка приводит к расширению сердца и вызывает сужение коронарных артерий.
Поэтому боли в области сердца могут носить характер приступов, иррадиировать в левое плечо, лопатку, челюсть, сниматься нитроглицерином.
Характер боли при перикардите и плеврите зависит от положения тела, усиливается при глотании, на вдохе, уменьшается при наклоне вперед.
Часть пациентов длительно чувствует себя нормально или не связывает утомляемость и одышку с болезнью сердца. Поэтому врачу нужно выяснить в беседе наличие начальных клинических проявлений.
Причины возникновения и особенности развития патологии
Причины кардиомегалии могут быть врожденные или приобретенные. К приобретенным относятся:
- Злокачественная артериальная гипертония.
- Пороки митрального, трикуспидального клапана или сочетанные.
- Острый либо хронический миокардит, эндокардит, перикардит.
- Распространенный атеросклероз сосудов.
- Кардиомиопатии.
- Ишемическая болезнь сердца.
- Гормональная кардиомиодистрофия.
- Злокачественные или доброкачественные опухоли сердца.
- Тромбофилия.
- Нарушение свертывающей и противосвертывающей систем крови.
- Патология легочной системы.
- Аутоиммуные системные заболевания.
Также «бычье сердце» может развиться у людей, длительно злоупотребляющих спиртными напитками, особенно пивом.
Врожденная кардиоомегалия в основном носит генетический характер. Предрасполагающими факторами для ее появления являются:
- Употребление алкоголя, табака, наркотиков в период беременности.
- Позднее наступление беременности (в возрасте старше 35 лет).
- Внутриутробное инфицирование вирусом герпеса, Эпштейна – Барра.
Употребление алкоголя – возможная причина кардиомегалии
Нужно понимать, что обычное увеличение сердца не является кардиомегалией. В норме масса миокарда и размеры этого органа могут быть увеличены у крупных высоких людей гиперстонического телосложения, у спортсменов. В данной ситуации речь идет о гипертрофии миокарда. Такое состояние не является патологией и не требует лечения.
При кардиомегалии под влиянием воспалительного или инфекционного процесса поражаются сердечные клетки (кардиомиоциты). При этом запускается аутоиммунная реакция, вырабатываются медиаторы воспаления, которые дополнительно разрушают сердечную мышцу.
Кардиомиоциты заменяются фиброзной (рубцовой) или соединительной тканью. Миокард теряет способность к эластическому растяжению. В результате снижается сократительная и насосная функции органа. Большое серце не в состоянии полноценно перекачивать кровь. В мышечной оболочке сердца возникают очаги склероза и дистрофии, его полости расширяются. При этом миокард может быть гипертрофированным или оставаться неизменным.
Кардиомегалия у плода и детей
Увеличение сердца, возникающее во время внутриутробного периода, является врожденным и очень серьезным заболеванием. Кардиомегалия у плода может развиться в связи с воздействием негативных факторов на беременную в период закладки сердечно-сосудистой системы, которая начинает развиваться у эмбриона очень рано – со второй по восьмую недели. То есть уже на 17-й день начинает оформляться кардиогенная пластинка, а к началу третьего месяца беременности у эмбриона уже формируется четырехкамерное сердце.
Итак, негативные факторы, оказывающие влияние на сердечно-сосудистую систему будущего ребенка:
- Ионизирующее, в том числе рентгеновское излучение, радиация,
- Вирусные заболевания матери, особенно краснуха, тяжелые штаммы гриппа, цитомегаловирусная инфекция, герпес и др,
- Курение, алкоголь, наркотики,
- Употребление некоторых препаратов, например, противосудорожных, барбитуратов и др,
- Жесткое нарушение диеты, голодание, истощение, серьезные авитаминозы.
Кроме этого, нельзя исключить наследственность, особенно по материнской линии.
Вследствие перечисленных факторов у плода могут сформироваться пороки сердца, например, аномалия Эбштейна, чаще других приводящая к умеренной кардиомегалии. Как правило, кардиомегалия у плода сочетается и с другими пороками развития, а также с врожденными хромосомными нарушениями, например, с синдромом Дауна. В небольшой части случае видимых сердечных причин для кардиомегалии у плода нет, поэтому такой тип болезни называется идиопатической кардиомегалией.
Симптоматика врожденного заболевания очень характерна и типична – у ребенка сразу после родов наблюдается цианоз лица или всего тела, одышка при плаче и сосании, выраженная тахикардия. Для подтверждения диагноза у новорожденных используют такие методы, как рентгенография органов грудной клетки и УЗИ сердца.
Прогноз врожденной кардиомегалии сомнительный, так как после родов младенцы выживают в 45% случаев, погибают – в 30% случаев, а оставшаяся часть детей имеет серьезные нарушения сердечной деятельности, однако, совместимые с дальнейшей жизнью.
Безусловно, в случае выявления причины, например, врожденного порока сердца у плода, приведшего к кардиомегалии, врачам действовать проще, в отличие от идиопатической формы заболевания, когда никакой видимой причины нет. Так, современное кадрово-техническое оснащение в некоторых перинатальных центрах и центрах сердечно-сосудистой хирургии, позволяет прооперировать малыша уже в первые дни после его появления на свет, а впоследствии выходить новорожденного и дать ему шанс на здоровое существование.
Кардиомегалия у детей раннего, дошкольного и школьного возраста формируется в случае некорригированных врожденных или приобретенных пороков сердца. Симптомы в основном сводятся к следующим признакам:
- Появление усталости, утомляемости,
- Плохому аппетиту,
- Нарушениям сна,
- Плохая успеваемость в школе,
- Неврологические нарушения,
- Психоэмоциональная лабильность.
Диагностика и лечение в случае приобретенной кардиомегалии мало чем отличается от таковых у взрослых людей.
Классификация кардиомегалии
В современной классификации выделяют несколько видов кардиомегалии:
- Врожденная. Возникает внутриутробно. Имеет тяжелое течение. Не подлежит консервативной терапии, всегда лечится оперативно.
- Идиопатическая. Может развиться у здоровых людей без объективных причин. Возникает редко.
- Приобретенная. В данном случае прогноз заболевания зависит от имеющихся хронических патологий сердечно – сосудистой системы.
- Физиологическая. Встречается у людей, имеющих избыточную массу тела или профессионально занимающихся спортом.
Также иногда встречается акогольная кардиомегалия. Ее основной причиной является неблагоприятное воздействие этанола на сердечную мышцу.
Существует еще одна классификация данного заболевания. Согласно ей кардиомегалия бывает:
- Дилатационная. Под влиянием патологических факторов снижается выработка сократительных белков, нарушается метаболизм кардиомиоцитов. Все полости сердца расширяются, возникает их дилатация.
- Рестриктивная. При этом заболевании сердце увеличено в размерах, но ведущим фактором является нарушение сократительной функции. Миокард при этом уплотнен и утолщен. Полости желудочков уменьшаются, а предсердия значительно расширяются. Повышается риск тромбозов и тромбоэмболических осложнений.
- Гипертрофическая. Наиболее часто встречающийся вид кардиоомегалии. В основном поражается миокард левого желудочка.
Также кардиомегалия может быть симметричной и асимметричной. При симметричном варианте все отделы сердца увеличиваются равномерно. При ассиметричном виде болезни утолщаются и гипертрофируются отдельные сердечные полости.
Алгоритм действий врача при обнаружении кардиомегалии
Если врач получает заключение об увеличенных размерах сердца, его тактика должна обязательно включать дальнейшее дообследование, выяснение причин, выбор плана лечения.
Алгоритм действий включает все этапы:
- Необходимо подтвердить истинность кардиомегалии.
- Поставить вопросы перед врачами диагностических кабинетов: какая именно из камер сердца увеличена и насколько, имеется ли гипертрофия или дилатация отделов.
- Выяснить причину с помощью опроса пациента, изучения документов, истории болезни.
- Оценить степень нарушения функции сердца.
- Проверить симптомы.
- Определить тактику терапии: профилактические меры (диета, режим, исключение факторов риска ишемии, антигипертензивные препараты); назначить необходимую дозировку лекарственных препаратов для лечения (гликозиды, мочегонные, β-блокаторы, нитропрепараты, антагонисты кальция); проконсультировать пациента по вопросу хирургического вмешательства (устранение порока сердца, стентирование коронарных артерий, шунтирование).
Клинические проявления
Клиника кардиомегалии сердца неспецифична. Ее проявления напоминают различные болезни сердечно – сосудистой системы. У больного возникают:
- Ощущение дискомфорта в грудной клетке, преимущественно в области верхушки сердца.
- Различные нарушения дыхания: тахипноэ, брадипноэ, ортопноэ.
- Тахикардия, синусовая или дыхательная аритмия, мерцательная аритмия.
- Чувство перебоев в сердце.
- Повышенная утомляемость, сонливость, слабость.
Также пациенты жалуются такие признаки кардиомегалии, как головокружения, шаткость при ходьбе, обмороки или предобморочные состояния. Однако следует помнить, что эти симптомы могут появиться и при других сердечных заболеваниях.
Симптоматика
На ранних этапах своего возникновения кардиомегалия протекает бессимптомно. И диагностировать ее удается после проведенных кардиологических исследований, назначенных специалистом по иным причинам.
Специфических клинических проявлений патология не имеет. Однако имеется ряд симптомов, сигнализирующих человеку обратиться за медицинской помощью:
- усиление одышки, ее появление даже при обычной физической нагрузке;
- нехарактерная ранее повышенная утомляемость;
- чрезмерно набухшие, выпирающие из-под кожи сосуды, переполненные кровью;
- выраженная отечность тканей, особенно нижних конечностей;
- часто возникающие болезненные ощущения в области проекции сердца.
У детей настораживающими признаками являются:
- отклонение параметров пульса от возрастной нормы, тахикардия;
- отсутствие аппетита в течение продолжительного времени;
- чрезмерная потливость даже при отсутствии физических перегрузок;
- бледный оттенок кожи в районе носогубного треугольника.
Своевременное обращение к кардиологу и вовремя предпринятые лечебные мероприятия многократно повышают шансы малыша на выздоровление.
Многие из вышеперечисленных симптомов могут быть отнесены к проявлениям иных заболеваний. Для кардиомегалии характерно скрытое течение, маскировка под различные сердечно-сосудистые расстройства.
Во время консультации человек указывает на такие жалобы, как дискомфорт в левой половине грудной клетки, возникающий после физической или психоэмоциональной нагрузки. Купировать подобное состояние удается приемом обычных успокоительных капель, к примеру, «Валокордина». Это отличительный признак от стенокардии, при приступе которой устранить болевые импульсы можно препаратами нитроглицеринового ряда.
Как правило, заподозрить наличие кардиомегалии удается после проведения диагностических процедур по поводу проявлений сердечной недостаточности. К ним относят:
- нарушения ритма;
- выраженную одышку;
- частые головокружения;
- понижение трудоспособности.
Многие люди продолжительное время находят различные оправдания подобному ухудшению собственного самочувствия, называя следующие причины:
- переутомление;
- малоподвижный образ жизни;
- перенесенные инфекционные патологии.
Тогда как раннее выявление и лечение помогают быстрее справиться с недугом.
Диагностика
Данное заболевание невозможно предположить после простого опроса и осмотра больного. Для диагностики кардиомегалии используют следующие инструментальные методы:
- ЭКГ. На записанной пленке определяются косвенные признаки патологии: гипертрофия левых или правых отделов сердца.
- Рентгенография грудной полости. При кардиомегалии на рентгенограмме можно увидеть увеличение размеров сердца. Также на снимке выявляется расширение желудочков или предсердий.
- МРТ сердца. С помощью этого метода диагностируют вес миокарда, его толщину, наличие патологических изменений в полостях.
- ОАК, биохимический анализ, ПТИ, кровь на свертываемость. Проводятся для выявления воспалительных, аллергических или аутоиммунных нарушений.
- Ультразвуковое исследование. Один из самых эффективных способов. Благодаря ему можно выявить степень выраженности патологии, определить функциональную способность миокарда.
ЭКГ – метод диагностики кардиомегалии
Также для диагностики кардиомегалии используют биопсию, сцинтиографию сердечной мышцы или катетеризацию миокарда. Диагноз выставляется только после инструментального подтверждения болезни.
Обязательно проводят диф.диагностику с миокардитом, инфекционным эндокардитом, врожденными и приобретенными пороками сердца.
Почему увеличивается сердце у ребенка?
Кардиомегалия может быть врожденной и обнаруживаться у плода при УЗИ исследовании беременной. Эта патология считается очень редкой, но опасной. Около 1/3 новорожденных с выявленной подобной патологией умирают в первые 3 месяца. А у 1/4 формируется хроническая левожелудочковая недостаточность.
Установлены следующие причины патологии у детей:
- инфекционные болезни матери во время беременности;
- курение матери;
- неблагоприятная экология, ионизирующая радиация;
- мутация на генетическом уровне;
- врожденные пороки сердца.
Формирование аномалии Эбштейна, редкого врожденного порока (1% от всех видов) связывают с развитием кардиомегалии. Порок образуется комбинированным поражением:
- трехстворчатого клапана в правом атриовентрикулярном отверстии;
- незаращением межпредсердного овального отверстия;
- уменьшением размеров правого желудочка.
Размеры сердца плода увеличиваются в 2 раза. Одновременно в полостях выявляются тромбы.
Приобретенная патология в детском возрасте связана с перенесенными инфекциями, осложненными аллергическими миокардитами.
Методы терапии
Синдром кардиомегалии лечится консервативно и оперативно. Выбор необходимого метода терапии определяется врачом – кардиологом или кардиохирургом.
Данную патологию невозможно устранить без лечения основного заболевания. Медикаментозная терапия показана взрослым и детям, при врожденной или приобретенной форме заболевания.
Больным рекомендуют соблюдение диеты с органичением соли, жидкости, жирной и жареной пищи. Также необходимо ограничение психоэмоциональных нагрузок, контроль за пульсом и артериальным давлением.
Медикаментозные
Для консервативного лечения кардиомегалии применяют следующие группы лекарственных препаратов:
- Сердечные гликозиды. Снижают потребность миокарда в кислороде, нормализуют все сердечные функции. Расширяют коронарные вены и артерии, нормализуют метаболические процессы.Увеличивают сократительную способность сердца.
- Петлевые, тиазидные или калийсберегающие диуретики. С их помощью можно вывести из организма воду, устранить периферические отеки. Благодаря такому эффекту эти препараты значительно снижают нагрузку на миокард.
- Ингибиторы АПФ. Снижают артериальное давление, способствуют обратному развитию гипертрофии левого желудочка. Восстанавливают сосудистый тонус.
- Бета – блокаторы и антиритмические препараты. Нормализуют сердечный ритм, урежают частоту сердечных сокращений. Расширяет сосуды, кровоснабжающие миокард, нормализуют скорость кровотока.
- Метаболические и антиангинальные препараты. Они улучшают показатели гемодинамики, увеличивают коронарный резерв.
Иногда применяют комбинированную терапию: сочетание лекарственных средств с хирургической операцией.
Оперативное вмешательство
Применяется при отсутствии эффекта от остальных вариантов лечения. К основным видам хирургических вмешательств относятся:
- Установка ЭКС.
- Замена сердечного клапана искуственым или биопротезом.
- Аорто – коронарное шунтирование.
В тяжелых случаях, при декомпенсации сердечной деятельности рекомендуют проведение трансплантации сердца.
Прогноз
При диагностировании бычьего сердца у человека, сказать, сколько живут с патологией по прогнозу больные, врач однозначно не сможет. Для детей с врожденным заболеванием прогноз в половине случаев плохой, так как 50% младенцев с нарушением погибают сразу после рождения, а третья часть выживших – в первые 3 месяца жизни. В остальных случаях терапия позволяет улучшить состояние больного, но риск внезапной смерти высокий, поэтому прогноз остается серьезным.
У взрослых с приобретенной формой заболевания он зависит от причины развития бычьего сердца и стадии, в которой была обнаружена патология. У большей части больных при своевременном обнаружении заболевания поддерживающая терапия дает положительный результат, из-за чего прогноз становится относительно благоприятным.
Кардиомегалия относится к тяжелым патологиям сердечной мышцы, которые требуют обязательного медицинского лечения. В зависимости от формы заболевания и его причины прогноз для больного изменяется.
Понравилась статья? Сохраните ее!
Остались вопросы? Задавайте их в комментариях! На них ответит врач-кардиолог Мариам Арутюнян.
Иван Грехов
Окончил Уральский государственный медицинский университет по специальности «Лечебное дело». Врач-терапевт
Возможные осложнения
К основным осложнениям кардиомегалии относятся:
- Сердечная недостаточность.
- Тромбозы.
- Легочная эмболия.
- Нарушение сердечного ритма.
Сердечная недостаточность – возможное осложнение кардиомегалии
Вероятность возникновения негативных последствий кардиомегалии напрямую зависит от стадии выявления заболевания. При ранней диагностике патологии риск осложнений уменьшается. При позднем обращении к врачу и отсутствии лечения возможность появления осложнений увеличивается.